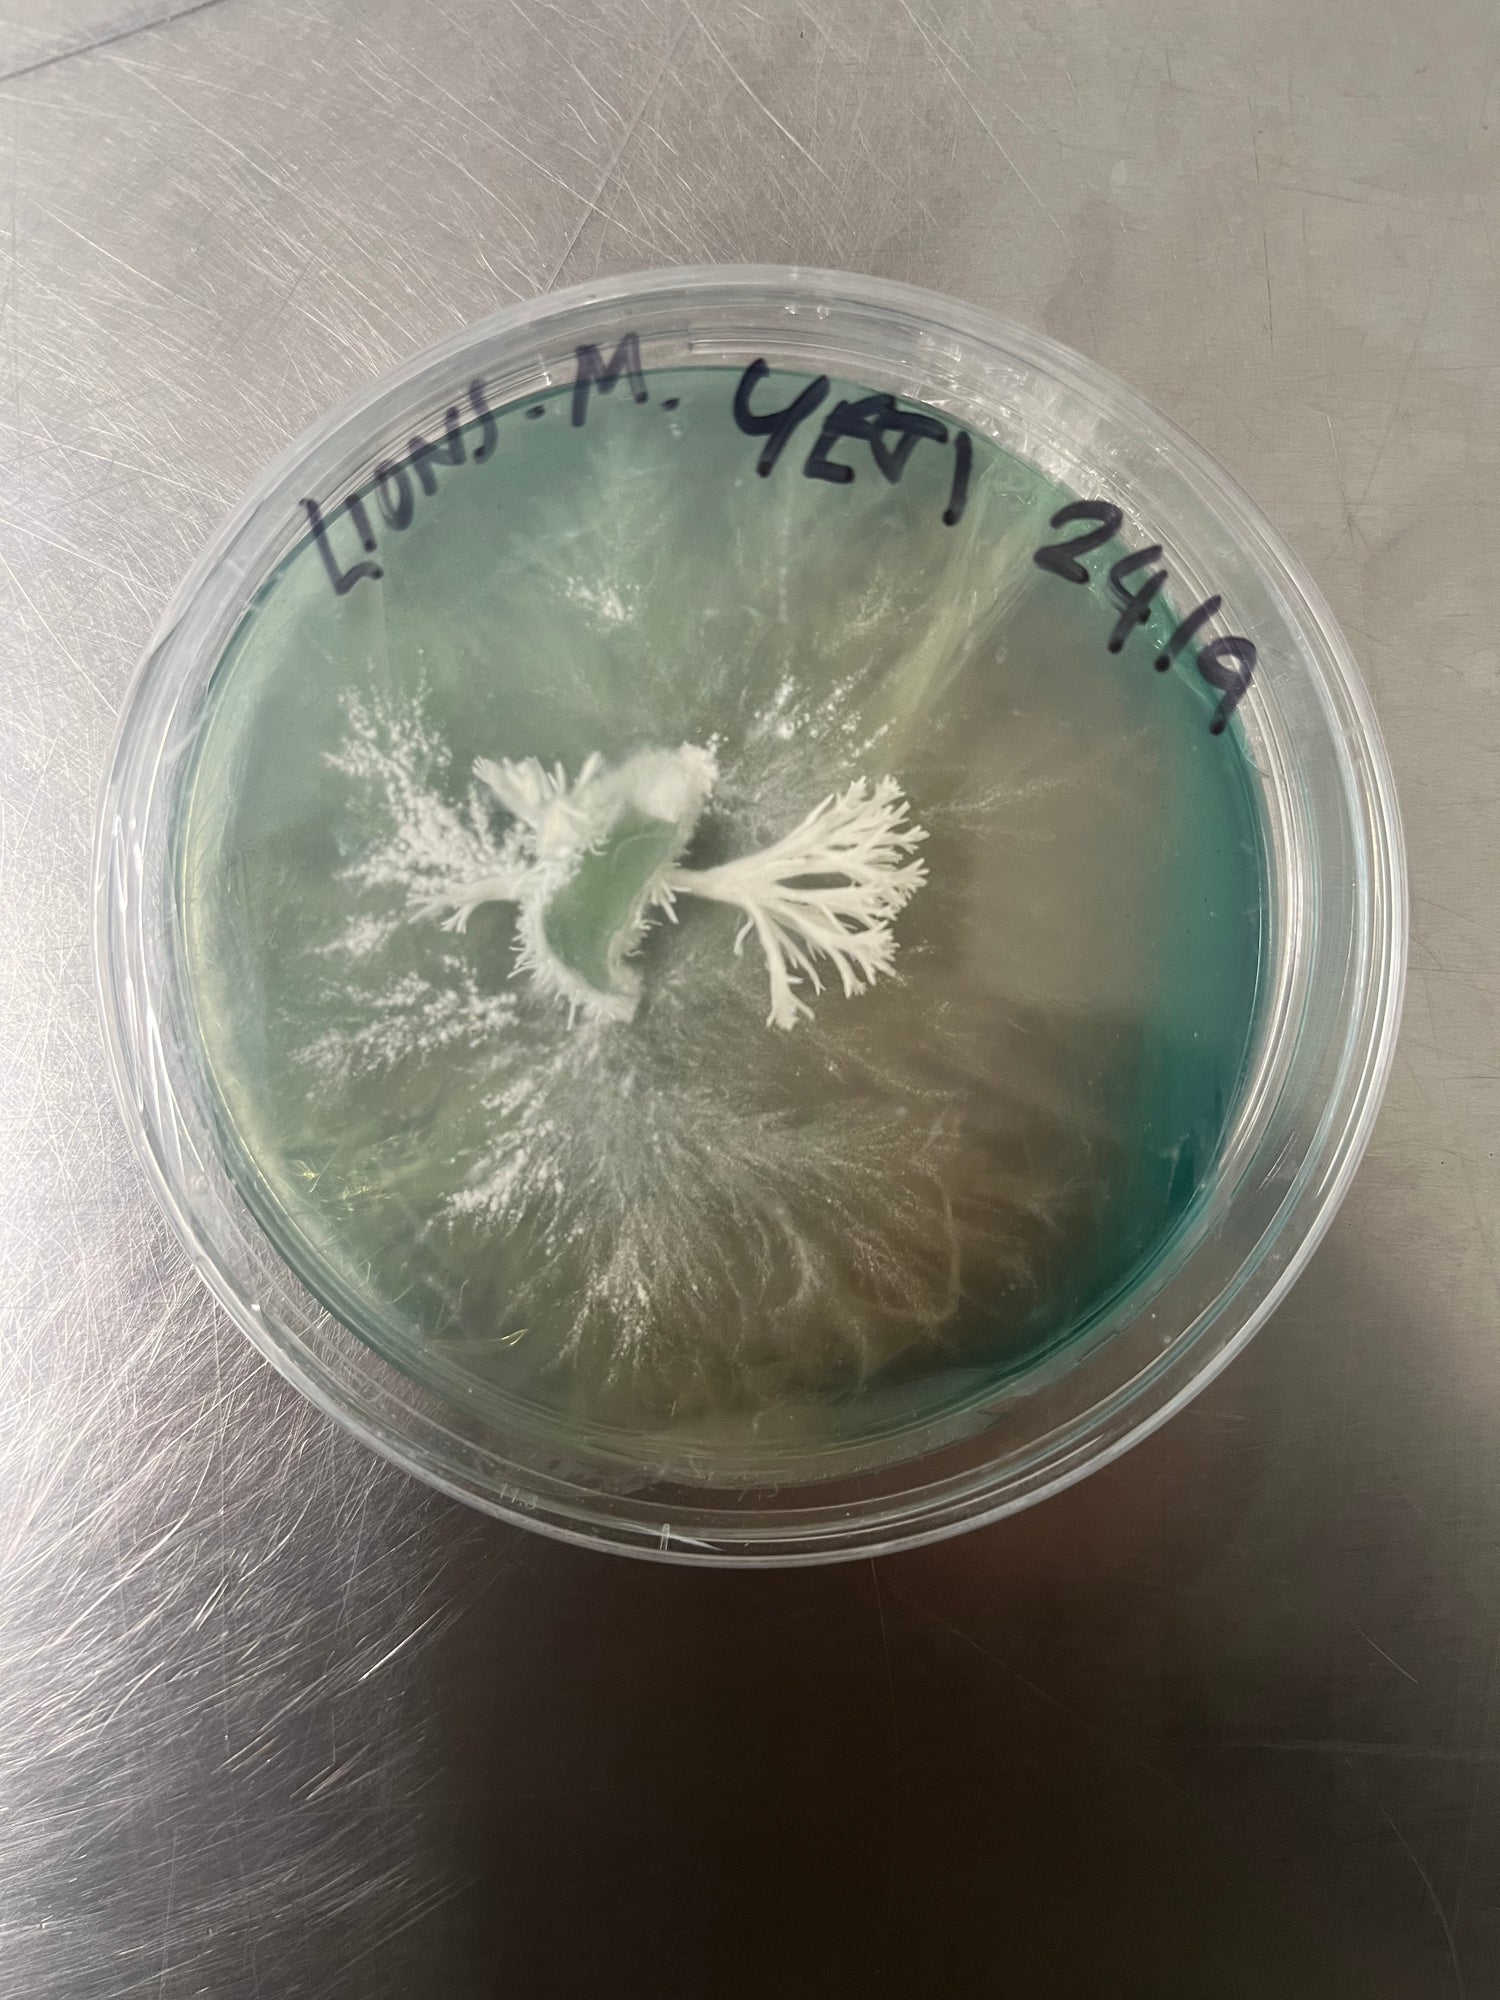

Stockport Fungi offers in-depth grow courses and arts workshops exploring the hidden secrets of the world’s most strange and beautiful organism. Covering everything from foraging and cultivation to artisan bowl and paper making, there is no other living thing quite like Fungi. Join us!
If you'd like us to deliver a workshop please get in touch.

WORKSHOP
Grow Your Own Mushrooms
In this workshop we’ll show you how to grow delicious oyster mushrooms from recycledand repurposed materials. You’lltake away your own kit to watch your mushrooms grow that you can reuse,saving rubbish from landfill and learning a terrific newskill.

WORKSHOP
Grow Outdoors
This inoculation class teaches you how to cultivate mushrooms in a garden or outdoor space. Through this simple, fun method, you’ll produce oysters, shiitakes and turkey tail mushrooms wherever you are. There’s options to inoculate pre existing flower beds or containers or we provided locally sourced felled logs.
WORKSHOPS
Mycology At Home
We’ll cover:
- Building a Still Air Box for clean work
- Cloning mushrooms onto agar plates
- Preparing and inoculating grain for spawn
- Tips for avoiding contamination and keeping your cultures healthy.
All materials are provided, and you’ll get to try hands-on techniques that allow you to grow mushrooms from tissue and liquid mycelium at home...giving you a long-term supply of your own mushrooms. No experience needed, maybe perfect for people who want to take their mushroom growing further.
By the end of the session, you’ll leave with your own agar plates and grain jars, plus the knowledge to keep your mycology lab going at home.

WOKSHOPS
Cooking With Mushrooms
Learn how to cook your mushrooms! In this session we will be joined by our wonderful chef friend and we shall explore the world of cooking with mushrooms.
We will be demonstrating several ways of cooking with Lions Mane and Oysters for you to try and we'll also be pickling our own mushrooms for you to take away.

WOKSHOPS
Fungi Art
We offer a range of fun, creative workshops that celebrate fungi in unexpected ways. Try mushroom drawing, mycelium sculpting, mushroom-based natural dyeing, or mycelium paper making...all designed to make you curious and connect you with the incredible world of mushrooms.
If you’d like to know more or arrange a workshop, please get in touch.
More Information
Please email if you’d like to book a private workshop and please check our events page for workshops coming up.


